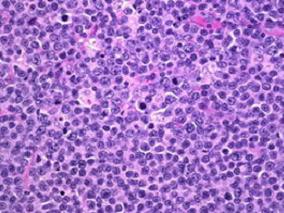
利妥昔单抗增加至短期强化化疗可改善成人伯基特淋巴瘤患者EFS

-
诊断后增加治疗强度不能提高AML成人患者的生成率
环球医学资讯
2016年07月15日
点击量:205
1小时条评论急性髓系白血病(AML)包括所有非淋巴细胞来源的急性白血病,是一个具有高度异质性的疾病群。2016年6月发表在《Leukemia》的一项由德国和美国科学家进行的研究表明,诊断时确定的治疗强度的增加并不会改善急性髓系白血病成年患者的生存率。 研究人员随机分配了3375...
-
乳腺癌辅助治疗预防心功能障碍:坎地沙坦vs美托洛尔
环球医学资讯
2016年07月14日
点击量:352
1小时条评论坎地沙坦主治原发性高血压。2016年6月发表在《Eur Heart J》的一项由挪威和德国科学家进行的研究表明,接受辅助含蒽环类治疗方案有/无妥珠单抗及辐射的早期乳腺癌患者,使用坎地沙坦的同步治疗为总体左心室功能的早期减弱提供保护作用。 目的:当代早期乳腺癌的辅助...
-
慢性髓系白血病患者基于伊马替尼方案治疗后的继发恶…
环球医学资讯
2016年07月14日
点击量:256
1小时条评论慢性髓系白血病(CML)是一种起源于多能干细胞的髓系增殖性肿瘤,死亡率非常高。2016年6月发表在《Leukemia》的一项由德国和瑞士科学家进行的研究考察了慢性髓系白血病患者基于伊马替尼的治疗后的继发恶性肿瘤情况。 酪氨酸激酶抑制剂(TKI)可以显著改善慢性髓系白...
-
PomCyDex或是难治性多发性骨髓瘤患者一种有效的全口…
环球医学资讯
2016年07月12日
点击量:244
1小时条评论泊马度胺和低剂量地塞米松是之前已接受过>2种治疗方案且来那度胺难治的多发性骨髓瘤患者的标准治疗方法。2016年5月,发表在《Blood》的一项研究表明,PomCyDex(泊马度胺+地塞米松+环磷酰胺)比泊马度胺联合地塞米松造成更高的总应答率。PomCyDex是难治性多发性骨髓...
-
Marizomib治疗复发/难治MM的最大耐受剂量
环球医学资讯
2016年07月12日
点击量:1928
1小时条评论Marizomib(MRZ)是一种不可逆的泛蛋白酶抑制剂,具有抗肿瘤活性。2016年6月,发表在《Blood.》的一项开放标签的剂量递增研究旨在确定MRZ的最大耐受剂量和2期研究推荐剂量。 Marizomib(MRZ)是一种新型的不可逆的蛋白酶抑制剂,用于治疗复发性或难治复发性多发性骨...
-
利妥昔单抗增加至短期强化化疗可改善成人伯基特淋巴…
环球医学资讯
2016年07月12日
点击量:404
1小时条评论短期强化化疗是成人伯基特淋巴瘤/白血病的标准治疗方案。2016年6月,发表在《Lancet》的一项随机、对照、开放标签的3期试验表明,利妥昔单抗增加至短期强化化疗可改善成人伯基特淋巴瘤患者无事件生存(EFS)。 背景:短期强化化疗是成人伯基特淋巴瘤/白血病的标准治...
-
多发性骨髓瘤自体干细胞移植后单次不劣效于连续高剂…
环球医学资讯
2016年07月11日
点击量:120
1小时条评论2016年6月,发表于《Br J Haematol》的一项研究比较多发性骨髓瘤自体干细胞移植后单次vs连续高剂量马法兰的长期结果。结果显示单次疗法不劣效于连续疗法。 这项前瞻性、随机III期试验GMMG-HD2旨在证实新确诊的多发性骨髓瘤(MM)自体干细胞移植后单次(A组)vs连续...
-
厄贝沙坦可用于治疗转移性结直肠癌?
环球医学资讯
2016年07月11日
点击量:159
1小时条评论用于治疗高血压的厄贝沙坦有新的用途。2016年5月。发表在《Ann Oncol》的一项研究显示,厄贝沙坦用于转移性结直肠癌,患者发生显著和持久性的应答。 背景:对于转移性结直肠癌患者,评估治疗相关毒性和放化疗抵抗作为个性化肿瘤治疗的一部分以寻找潜在替代治疗策略...
-
醋酸阿比特龙联合泼尼松用于三阴性AR阳性局部晚期或…
环球医学资讯
2016年07月11日
点击量:473
1小时条评论2016年5月,发表在《Ann Oncol》的一项研究评估了醋酸阿比特龙(AA)+泼尼松用于三阴性AR阳性局部晚期或转移性乳腺癌的有效性和安全性。结果显示,AA加泼尼松对一些分子顶浆分泌乳腺癌患者有益。 背景:一些表达阵列研究确定了分子顶浆分泌乳腺癌(BC)作为表达雄激...
-
贝伐珠单抗可有效治疗神经纤维瘤2型导致的听觉损失
环球医学资讯
2016年07月06日
点击量:655
1小时条评论神经纤维瘤病(NF)是一种在神经通路上有肿瘤生长的疾病,可分为两种类型神经纤维瘤病 1 型(NF1)和神经纤维瘤病 2 型(NF2)。NF2 是一种常染色体显性遗传性斑痣性错构瘤病。2016年5月,发表在《J Clin Oncol》上的一项研究显示,贝伐珠单抗治疗能使36%的NF2且已证...

会员登录

